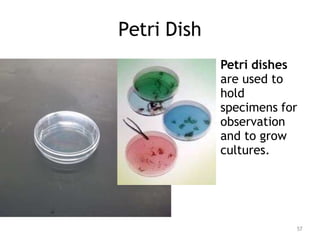
Petri Dish
Petri dishes
are used to
hold
specimens for
observation
and to grow
cultures.
57

This document provides descriptions and uses for common laboratory equipment. It defines key terms like accuracy, precision, physical properties, and chemical properties. It also explains how to properly use items like balances, rulers, and pipettes to make accurate measurements. A variety of common lab tools are described, including beakers, flasks, funnels, clamps, burners, and personal protective equipment like goggles and aprons. Less common equipment like centrifuges and petri dishes are also briefly outlined. The document serves as a review of essential lab equipment, techniques, and terminology.